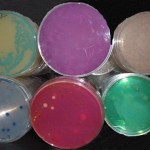
placas

Placas preparadas de 90 mm de larga caducidad (25 ml de medio con antiburbujas) para siembra en superficie: estría, extensión o sedimentación
Placas preparadas únicas: con 3 meses de caducidad real. Con los medios preparados ahorrará tiempo y trabajo. Ganará en comodidad al ahorrarse la tarea de pesar, calentar, disolver, ajustar el ph, autoclavar y dispensar los medios de cultivo deshidratados; así como controlor que cada lote que se ha preparado es apto en calidad, productividad, selectividad . . .
Conscientes de la desesperación de los usuarios a causa de recibir generalmente las placas preparadas de otros fabricantes con muy escasa caducidad (a menudo de menos de 1 mes y a veces de sólo 1-2 semanas), hemos diseñado las primeras placas con 25 ml de medio en lugar de los 15 ml habituales, que fabricamos bajo pedido, lo que nos permiten asegurar a su recepción, nada menos que 3 meses de caducidad desde fabricación. Si necesita placas preparadas de larga caducidad consúltenos probablemente podremos preparárselas a partir de sólo 40u.
Consulte nuestra amplia gama de medios de cultivo preparados.
En MICROKIT tenemos todos los medios de cultivo que Ud. necesita, con la garantía de un fabricante que lleva cerca de un cuarto de siglo haciendo lo que mejor sabe hacer: facilitar el trabajo a laboratorios de microbiología con los más rigurosos estándares de calidad.
Para cualquier consulta que quiera realizar no dude en ponerse en contacto con nosotros a través de nuestra dirección de correo microkit@microkit.es o nuestro número de teléfono (91) 897 46 16.

Buenos Días, quería solicitar un presupuesto por las placas preparadas de Sabourand Dextosa con neutralizante y Triptona soja con neutralizante
Buenos dias, Respondemos a su consulta desde nuestro correo general. Muchas gracias por visitar nuestro blog y contactar con nosotros. Un cordial saludo.